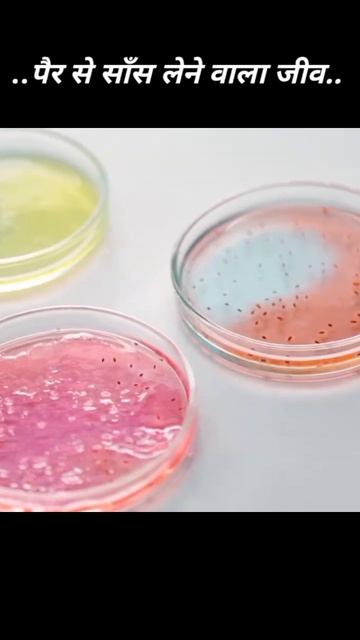
pair se sans lene vala jiv #facts #gyan #amazing #amazingfacts смотреть онлайн

Автор: Zoo Love Stories Страница 2

Алёна Сахнова

彩虹- cai hong guitar cover

Hathyar-Song by Sidhu moose wala (perfectly slow reverb)Sady kolu saim saim jo langdy se) Please su

Футбольные финты

ЧТО ТАКОЕ ЕЖЕВИКА📍ЧЕМ ПОЛЕЗНА ЕЖЕВИКА ДЛЯ ОРГАНИЗМА

DO ONE MINUTE MUG CAKE IN MICROWAVE || CHOCOLATE CAKE || AMY WINTER KITCHEN

Китовые акулы, Бохол, Филиппины

Fernando Delgadillo - Días de sombrillas

Senden Sonra Ben │Jojo Moyes

School of seduction / Школа соблазнения

🎬Мистика🔥|Код :489 |🎬 #фильм#момент#отрывок

Мон Платин отзывы: Музичук Светлана Витальевна г. Саратов

правой кидаеш левой хлеб прикрываешь(мем с годзи)#годзилла

//Cause I am on fire, a crying burning liar//VANESSA A.//(( FNaF gacha))

КАТЯ ТРУХИНА | SOLO ADULTS PRO | FRONT ROW | WAKE UP CHAMP 12/2023

Part 27: Restaurant Pavilion 🥗🌴{Planet Coaster}

🫣кит 52 герц

Лучший прыгун

EFES Fusion TVC
pair se sans lene vala jiv #facts #gyan #amazing #amazingfacts

Black Mamba Orion Pax aka Optimus Prime Transformers Toy

Попугай #кеша играется с подушкой

Чистим от накипи ТЭН бойлера.
![MIA KHALIFA PIC🫦 x [Lunglian x edit] x XML 🔰🔰 FILE 🗃️🗃️ x {ALIGHT MOTION PRESENT} смотреть онлайн](https://pic.rutubelist.ru/video/2025-04-17/2e/5c/2e5c5be5eeb7ab402ea8617797bebe8e.jpg?size=m)
MIA KHALIFA PIC🫦 x [Lunglian x edit] x XML 🔰🔰 FILE 🗃️🗃️ x {ALIGHT MOTION PRESENT}
За каждым успешным каналом стоит личность, идея и сотни часов кропотливого труда. Если вы здесь, значит, автор «Zoo Love Stories» уже сумел зацепить ваше внимание своим уникальным стилем или подачей. А мы на RUVIDEO позаботились о том, чтобы вы могли изучить весь архив его работ в максимально комфортных условиях — без лишней суеты и преград.
Почему за работами канала «Zoo Love Stories» так интересно наблюдать? Всё просто: это честный контент, который находит отклик в сердцах зрителей. На нашем ресурсе вы можете смотреть онлайн все видео любимого автора бесплатно и в хорошем качестве. Нам важно, чтобы вы видели каждую деталь и слышали каждый нюанс, поэтому мы используем только стабильные плееры из открытых источников Rutube.
Следите за новинками канала, пересматривайте старые шедевры и открывайте для себя новые грани творчества «Zoo Love Stories». Мы постоянно обновляем ленту, чтобы у вас под рукой всегда были самые свежие выпуски. Никаких сложных регистраций — только вы и творчество, которое вдохновляет. Приятного вам путешествия по миру авторского контента на RUVIDEO!
Видео взято из открытых источников Rutube. Если вы правообладатель, обратитесь к первоисточнику.